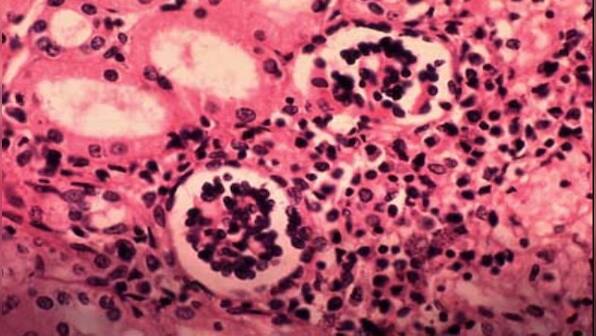

Quality and affordable health care for all is the most critical feature of a thriving nation. It is only when communities’ health care needs are successfully safeguarded, through strong public health systems and Universal Health Coverage (UHC), that we can hope to collectively move forward into a healthier, more productive future. A true test of a nation’s progress in ensuring UHC is in its ability to address diseases that are often overlooked and Neglected Tropical Diseases (NTDs) have been called a ‘litmus test’ for the efficacy of UHC. NTDs are a set of infectious conditions that mainly impact those that are already most vulnerable and impoverished. Diseases such as lymphatic filariasis, visceral leishmaniasis, soil transmitted helminths, or leprosy, are debilitating, disfiguring and stigmatising. They impact the lives of over a billion people worldwide, many of whom live in India. Today, we have the scientific and technological capacity to end NTDs once and for all. Global efforts to prioritise NTDs have increased and, in India, government programs to eliminate these diseases have received a much-required shot in the arm. Still, NTDs cause disease and disability among hundreds of thousands across the country. Lymphatic filariasis (LF) is the second greatest cause for disability in the world. It causes elephantiasis or haati pao, characterised by the swelling of legs to an extent that the patient cannot work and is often ostracised socially. Visceral leishmaniasis or Kala Azar, is a disease that can be fatal if treatment is not sought out in time. It too can cause stigmatisation and have life-long effects on sufferers. In Odisha, which has a high burden of LF, I have witnessed, first hand, examples of how access to free, high-quality health services can improve lives and safeguard livelihoods. People across the country who are already burdened by economic hardships, lack of access to water and sanitation or health care, have been protected from the burden of increased financial insecurity by free-of-cost preventative medication or insecticidal spraying. Proactive outreach by government and allied partners have served to reach the remotest communities, overcome barriers of stigma and shame, and support those truly in need. By December 2023, the Government of India plans to reduce kala-azar cases to less than one per 10,000 people at the block level and, by 2030, to eliminate haati pao as well. Starting 10 February 2023, India will conduct Mass Drug Administration (MDA) rounds in Mission Mode in 10 affected states. With Drug Administrators conducting door-to-door visits, this is a tremendous opportunity to sensitise communities across the country about why we must take anti-filarial drugs. Meanwhile, with kala-azar elimination targets close at our heels and only four blocks in Jharkhand still working to meet the targets, we must focus all our energies toward ensuring that program activities such as spraying, monitoring, case identification and treatment are prioritised by state level political and government officials. India is poised to ensure NTDs are eliminated once and for all. We must ensure a combination of rigorous and effective program implementation coupled with strong communications at the community level to raise awareness. Only by ensuring our communities have access to the health services they need, without suffering financial hardships, can we truly say we have begun to achieve our potential as a nation. The author is a former Member of Parliament from Odisha and a member of the Biju Janata Dal party. He is the Convenor of the National Coalition on Neglected Tropical Diseases and Malaria, a group that aims to prioritize elimination programs for these diseases. Views are personal. Read all the Latest News , Trending News , Cricket News , Bollywood News , India News and Entertainment News here. Follow us on Facebook, Twitter and Instagram.
Global efforts to prioritise NTDs have increased and, in India, government programs to eliminate these diseases have received a much-required shot in the arm. Still, NTDs cause disease and disability among hundreds of thousands across the country
Advertisement
End of Article

)

)
)
)
)
)
)
)
)
